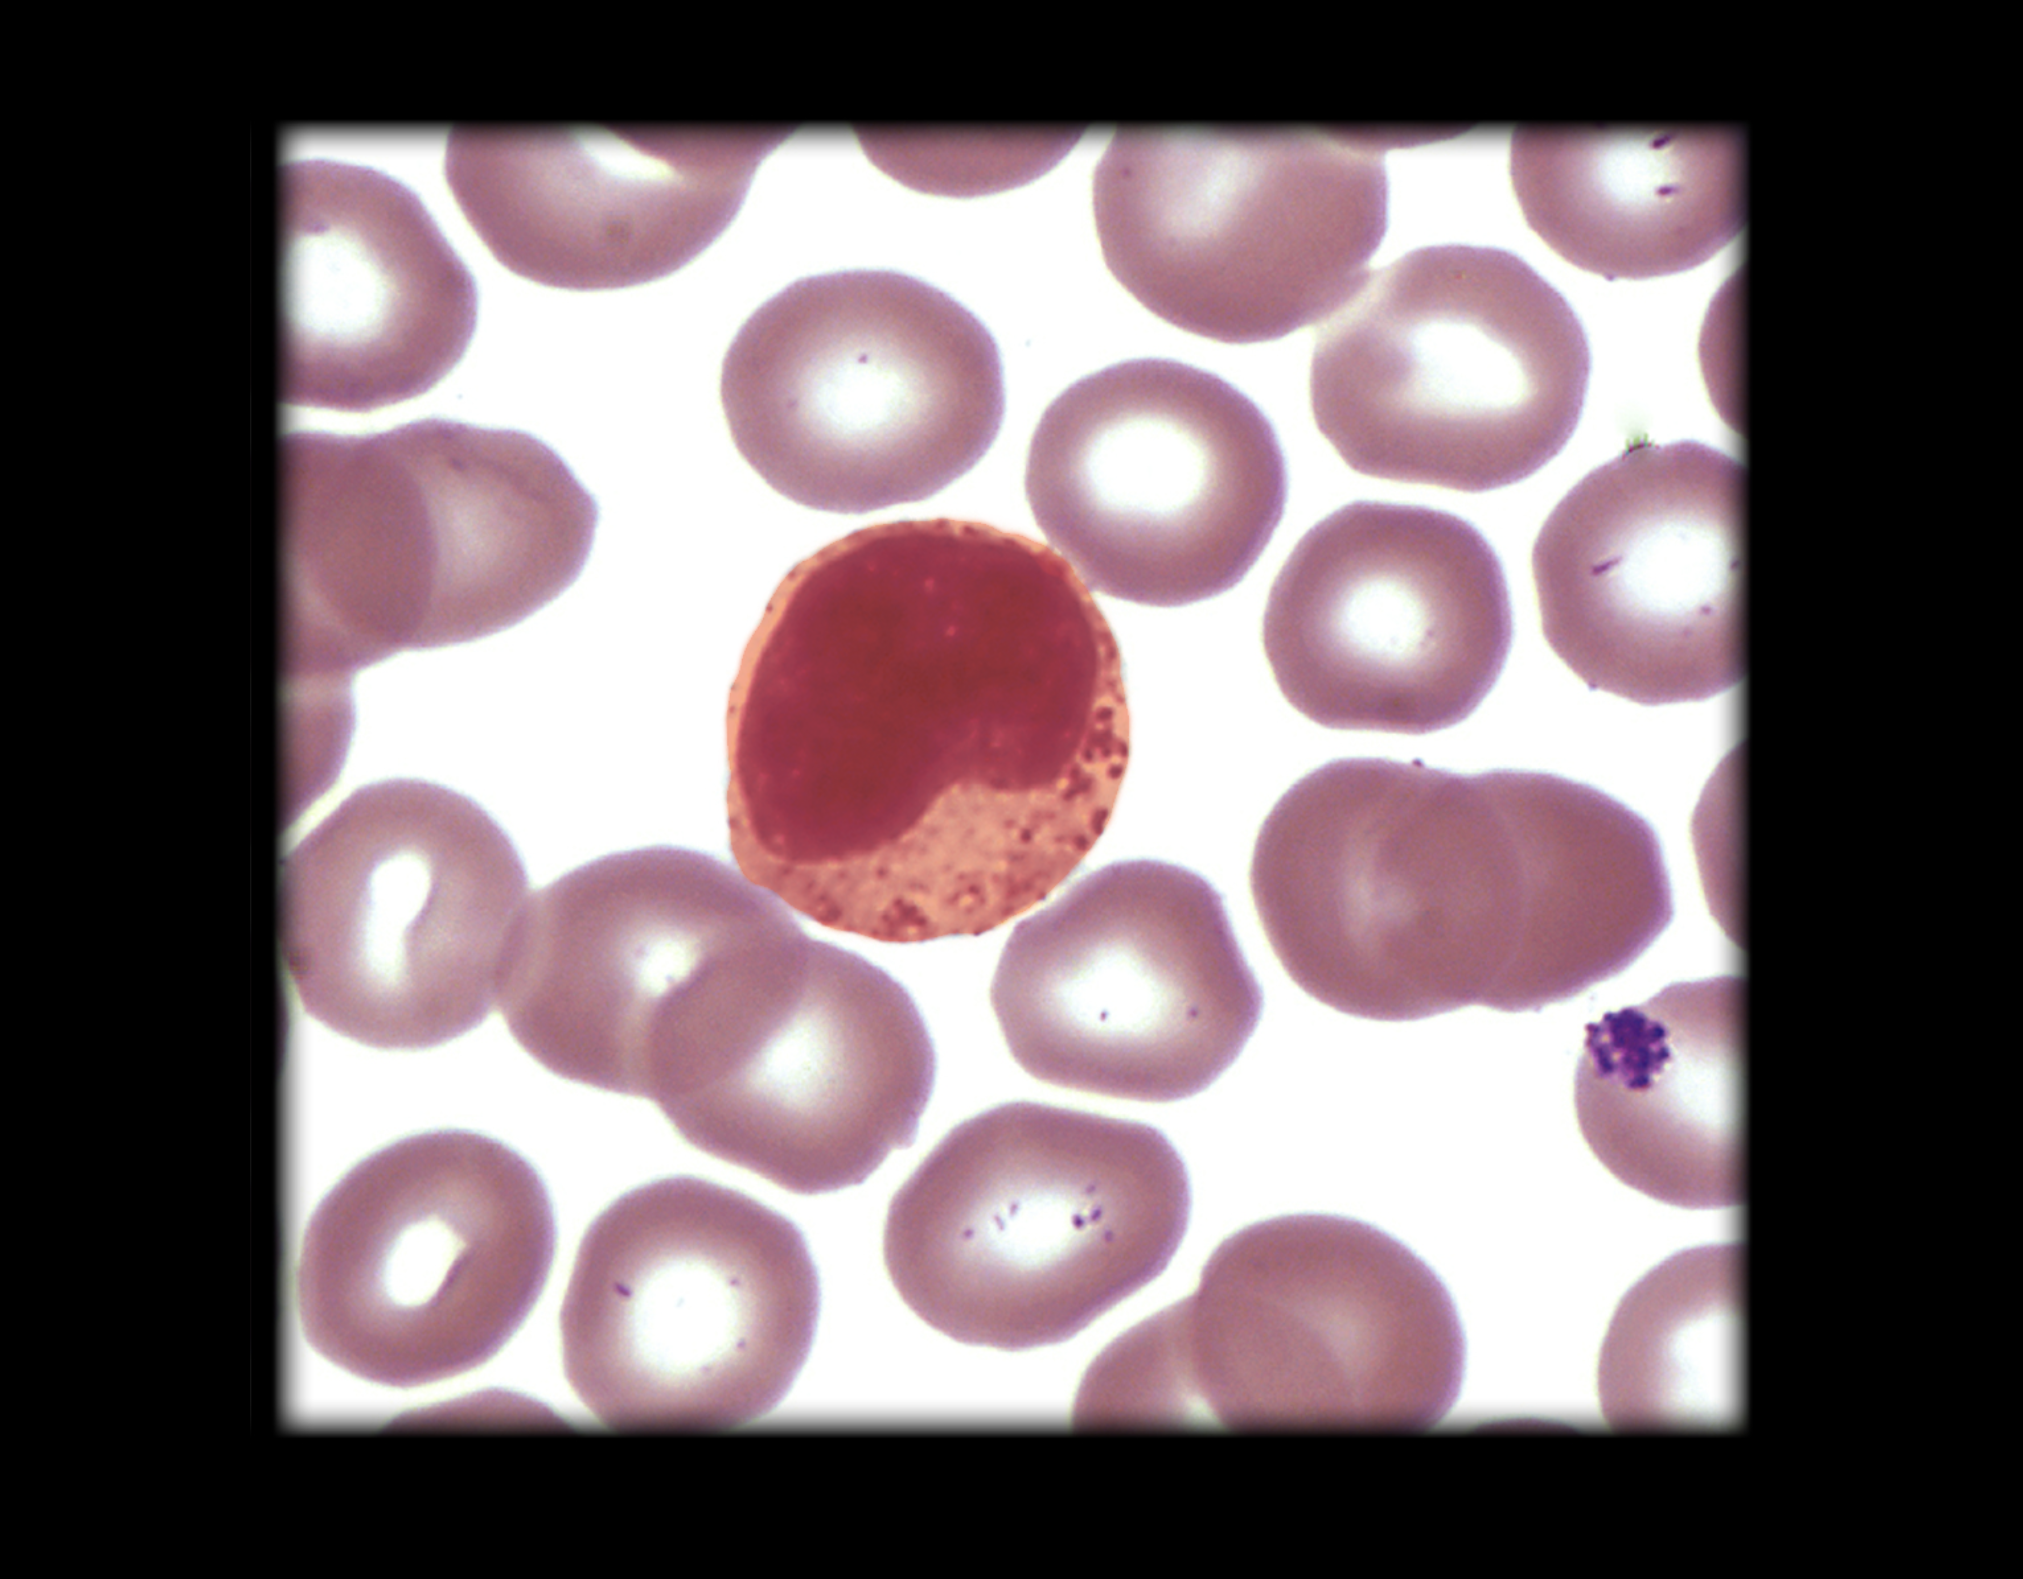
<p>look at giant red orange dot for monocytes</p>

1/4
Looks like no tags are added yet.
Name | Mastery | Learn | Test | Matching | Spaced | Call with Kai |
|---|
No analytics yet
Send a link to your students to track their progress
Monocyte
look at giant red orange dot for monocytes
Monocyte location
Circulating blood
Connective tissue
Monocyte description
Largest leukocyte (15-20 µm in diameter)
In connective tissue, they transform into macrophages
Monocyte function
Phagocytosis
Monocyte comment
Monocytes represent 3-8% of circulating leukocytes
Leukocytes (white blood cells) divided into two groups: granulocytes (neutrophils, eosinophils, and basophils) and agranulocytes (lymphocytes and monocytes)
Micrometer (µm) is 1/1,000 of a millimeter